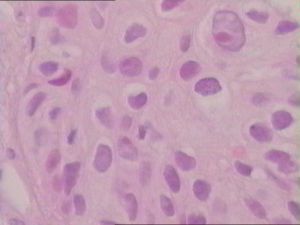
肺部良性腫瘤

臨床表現
 肺部良性腫瘤
肺部良性腫瘤絕大多數無臨床症狀和體徵,常在X線檢查時發現。部分病例可有症狀,如:咳嗽、聲嘶、肺部感染和咯血等。肺良性腫瘤根據其分類不同症狀也不同。周圍型良性腫瘤的大小及部位決定其表現,很少引起臨床症狀。少數患者可因瘤體較大、鄰近支氣管或其他不明原因而有臨床症狀,最常見咳嗽及非特異性胸痛,也可胸悶、咯血絲痰、乏力等。
中心型良性腫瘤的大小及活動度決定其表現,多數病例有明顯的症狀及體徵。體積較小的氣管、支氣管腫瘤,多無任何症狀。而較大的腫瘤,因不完全地阻塞氣管,可聞及喘鳴音。
肺部良性腫瘤症狀診斷
一、症狀絕大多數無臨床症狀和體徵,常在X線檢查時發現。良性腫瘤可有症狀:咳嗽、聲嘶、肺部感染和咯血等。肺良性腫瘤根據其分類不同症狀也不同。
周圍型良性腫瘤的大小及部位決定其表現,很少引起臨床症狀,60%以上無症狀,僅查體時放射學檢查偶然發現,近90%查體無相關體徵。少數病人可因瘤體較大、鄰近支氣管或其他不明原因而有臨床症狀,最常見咳嗽及非特異性胸痛,也可胸悶、咯血絲痰、乏力等。
中心型良性腫瘤的大小及活動度決定其表現,多數病例有明顯的症狀及體徵。體積較小的氣管、支氣管腫瘤,多無任何症狀。而較大的腫瘤,因不完全地阻塞氣管,可聞及喘鳴音。如果腫瘤大部或完全地阻塞呼吸道,引起:①支氣管內分泌物的清除受限,可導致反覆發作的肺炎、支氣管炎、肺膿腫等;②通氣受限導致遠端肺不張或肺氣腫。表現為咳嗽、咳痰、胸痛、發熱、喘鳴甚至咯血等症狀。
肺部良性腫瘤切除多久能好?
第一:肺部良性腫瘤切除需要經驗3個月的,肺部手術後進行養肺這是毋庸置疑的,以肺補肺一直都受到人們的推崇,所謂以形補形。下面這道豬肺湯就有補益肺部的功效。做法:選新鮮豬肺洗淨切成小方塊,放入沸水中滾5分鐘撈出備用。再把川貝母拍碎,雪梨去心切塊。在準備一鍋熱水煮沸,把食材通通倒進去中火煮兩個小時。出鍋前稍加調味料就可以了。第二:杏仁油清肺的功效,山藥營養豐富,把它們同煮也是很適合肺部手術後的病人的。做法:雪梨去心去皮切成小塊,山藥切小塊,連同杏仁放入攪拌機攪成糊狀,倒在碗裡,加白糖攪拌成糊狀,加水在爐上熱一下就可以吃了。
第三:由於肺部曾長過腫瘤,所以術後防癌抗癌的工作也是不能少的。我們只知靈芝是補品,可知道它也是防癌的好東西。下面就介紹一道靈芝湯。選用新鮮鮑魚,洗淨切片備用,靈芝洗淨切小塊。準備其他配料:桂圓乾、蔥姜。讓後下一鍋水,煮沸後把食材放下,用小火燉一個小時,家適量鹽就可以出鍋了。
檢查
X線胸片、體層攝影、支氣管造影、CT掃描等檢查對於顯示和分析肺部良性腫瘤的特徵具有較高的診斷價值,最後確切診斷依靠病理組織學檢查。治療
肺部良性腫瘤
肺部良性腫瘤
